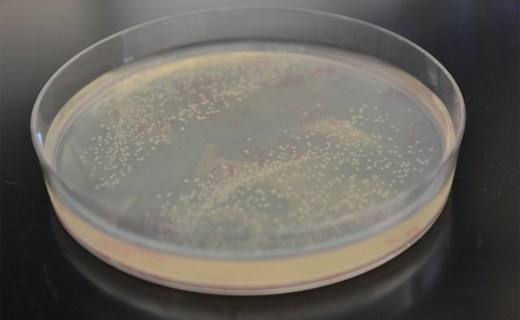
image

Znanstvenici majmunima stvorili lažni osjećaj dodira

Protetika je u posljednjih nekoliko godina doživjela veliki napredak. Hi-Tech protetska pomagala, bioničke ruke i drugi udovi, sve su učinkovitija što se tiče funkcionalnosti, pa se sada znanstvenici više ne bave toliko mehaničkim svojstvima , već žele ljudima pružiti pravi osjećaj dodira . Nedavno smo pisali o švicarskim znanstvenicima koji su proizveli protetsku ruku s dodirnim senzorima koji se spajaju na dva glavna živca ruke , čime se pacijentima djelomično vraća osjećaj dodira, a novo istraživanje znanstvenika Sveučilišta u Chicagu...
- Objavljeno u Znanost